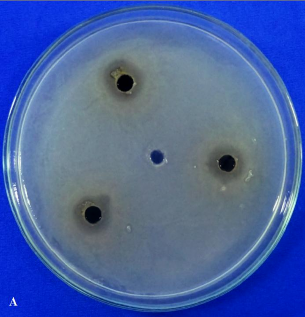
Hình 3 12 Kết quả đường kính vòng vô khuẩn đối với vi khuẩn Xanthomonas của 1
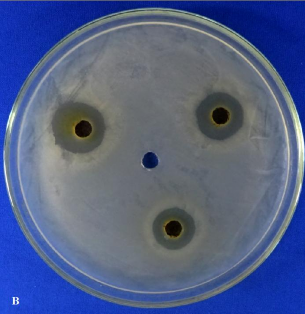
Hình 3 12 Kết quả đường kính vòng vô khuẩn đối với vi khuẩn Xanthomonas của 2
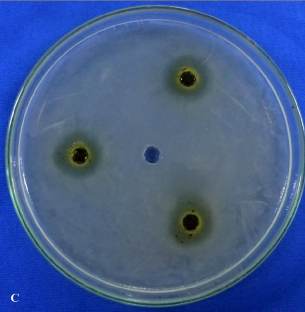
Hình 3 12 Kết quả đường kính vòng vô khuẩn đối với vi khuẩn Xanthomonas của 3

3.2.1. Kết quả tạo cao chiết toàn phần và các cao phân đoạn từ cây giao (Euphorbia tirucalliL.)
Bột khô (6,5 kg) của cây giao (E. tirucalli) thu thập ở 3 vùng Phan Thiết, Tp. Hồ Chí Minh và Đắk Nông có độ ẩm tương ứng 8,73% ± 0,74; 8,86% ± 0,69; 8,67% ± 0,87 được sử dụng trong nghiên cứu. Kết quả hiệu suất chiết và độ ẩm cao toàn phần và các cao phân đoạn từ cây giao thu thập ở Bình Thuận, Đắk Nông, Tp. HCM được trình bày trong Bảng 3.5 và Bảng 3.6.
Qua Bảng 3.5 và Bảng 3.6 cho thấy, với độ ẩm các cao toàn phần và cao chiết phân đoạn nằm trong khoảng 27,28 ÷ 30,71% (Bảng 3.6), hiệu suất chiết cao toàn phần (EtOH) của cây giao thu nhận ở ba vùng Bình Thuận, Đắk Nông và Tp. HCM khác biệt nhau đáng kể. Trong đó, cây giao thu nhận ở Phan Thiết, Bình Thuận có hiệu suất chiết cao toàn phần cao nhất đạt 9,48% và thấp nhất là cây giao thu nhận ở Tp. HCM (8,67%). Hiệu suất chiết cao toàn phần (EtOH) trong nghiên cứu này khác so với hiệu suất chiết cây giao thu nhận ở Ấn Độ trong báo cáo của Upahyay và ctv (2010).
Bảng 3.5. Kết quả hiệu suất chiết cao toàn phần và các cao phân đoạn từ cây giao thu thập ở Bình Thuận, Đắk Nông và Tp. HCM
Loại cao chiết | Hiệu suất chiết (%) | |||
Đắk Nông | Bình Thuận | Tp. HCM | ||
1 | EtOH | 8,87b | 9,48c | 8,67a |
2 | He | 29,79a | 29,04a | 31,13b |
3 | EA | 18,34b | 18,64b | 15,92a |
4 | Bu | 13,14b | 11,90a | 15,22c |
Có thể bạn quan tâm!
-
Xác Định Hàm Lượng Các Hợp Chất Có Trong Cao Chiết Phân Đoạn Có Hoạt Tính Ức Chế Vi Khuẩn X. Axonopodis Cao Nhất -
Kết Quả Khảo Sát Khả Năng Gây Bệnh Của Các Mpl X. Axonopodis Pv. Citri -
Xác Định Loài Xanthomonas Sp. Dựa Vào Trình Tự Vùng Gene 16S Rdna -
Hàm Lượng Phenolic Tổng Và Flavonoid Tổng Của Cao Chiết Phân Đoạn Từ Cây Giao (E. Tirucalli) -
Hợp Chất 3,3’,4-Tri-O-Methylellagic Acid (Hợp Chất 4) -
Hiệu Quả Phòng Trừ Bệnh Loét Trên Cây Chanh Của Cao Ea Ở Các Nồng Độ Khác Nhau Trong Điều Kiện Nhà Lưới
Xem toàn bộ 232 trang tài liệu này.
Trong cùng một hàng, các giá trị có các ký tự theo sau khác nhau chỉ sự khác biệt có ý nghĩa thống kê ở mức 0,05 theo trắc nghiệm DUNCAN; EtOH: cao toàn phần ethanol; He: cao n-hexan; EA: cao ethyl acetate; Bu: cao butanol
Bảng 3.6. Độ ẩm của cao toàn phần và các cao phân đoạn từ cây giao thu thập ở Bình Thuận, Đắk Nông và Tp. HCM
STT Loại cao chiết Độ ẩm (%)
Đắk Nông Bình Thuận Tp. HCM
1 EtOH 29,18±1,12 29,68±0,60 27,96±0,84
2 He 27,51±0,80 27,28±0,99 27,99±0,87
3 EA 29,00±1,48 29,05±0,60 29,23±0,89
4 Bu 30,71±0,86 30,47±0,69 30,27±1,09
EtOH: cao toàn phần ethanol; He: cao n-hexan; EA: cao ethyl acetate; Bu: cao butanol
Theo Upahyay và ctv (2010), hiệu suất chiết cây giao trong dung môi methanol bằng phương pháp soxhlet ở nhiệt độ 54,0 ÷ 55,5oC trong 24 đến 36 giờ đạt 4,44%. Giữa các cao phân đoạn, hiệu suất chiết cao ethyl acetate từ cây giao ở Bình Thuận là cao nhất (18,64%), khác biệt không đáng kể so với cây giao thu ở Đắk Nông (18,34%). Tuy nhiên, cây giao thu nhận ở Tp. HCM có hiệu suất chiết cao n-hexan và cao butanol cao nhất tương ứng 31,13 và 15,22%. Kết quả nghiên cứu phù hợp với nhận định của các nghiên cứu trước, thành phần và hàm lượng các hợp chất thứ cấp trong thực vật phụ thuộc vào các yếu tố như tuổi cây, vị trí địa lý, khí hậu (Upadhyay và ctv, 2010); thành phần các hợp chất trong dịch chiết phụ thuộc vào độ phân cực và trọng lượng của dung môi chiết (Younes và ctv, 2018); dung môi không phân cực hòa tan tốt các hợp chất không phân cực, dung môi có tính phân cực trung bình sẽ hòa tan tốt các các hợp chất phân cực trung bình, dung môi phân cực mạnh sẽ hòa tan tốt các các hợp chất phân cực mạnh (Nguyễn Kim Phi Phụng, 2007).
3.2.2. Đánh giá hoạt tính ức chế vi khuẩnX. axonopodis pv. citri của các cao chiết phân đoạn
Việc đánh giá hoạt tính ức chế vi khuẩn X. axonopodis của các cao chiết phân đoạn từ cây giao từ 3 vùng thu nhận (Bình Thuận, Đắk Nông, Tp. HCM) trong điều kiện phòng thí nghiệm là rất cần thiết vì đây chính là cơ sở để xác định vùng thu nhận
cây giao, phân đoạn cao chiết và nồng độ thích hợp cho việc ứng dụng ngoài đồng. Kết quả đường kính vòng vô khuẩn và giá trị MIC của các cao chiết phân đoạn được thể hiện trong Bảng 3.7, Bảng 3.8 và Hình 3.13.
Bảng 3.7. Đường kính vòng vô khuẩn của các cao chiết phân đoạn đối với vi khuẩn
X. axonopodis pv. citri
Vùng thu
Cao chiết phân
Đường kính vòng vô khuẩn (mm)
Nồng độ (mg/mL)
nhận đoạn
1,25 | 2,5 | 5,0 | 7,5 | |
Bình He | - | - | 6,10±0,65 | 8,67±0,76 |
Thuận EA | 10,57±0,80 | 12,30±0,79 | 14,33±0,76 | 17,67±0,57 |
Bu | 3,70±0,30 | 7,63±0,65 | 10,03±0,55 | 11,03±0,35 |
Đắk He | - | - | 3,07±0,60 | 5,77±0,75 |
Nông EA | 8,67±0,29 | 10,17±0,29 | 12,23±0,87 | 15,5±0,50 |
Bu | 3,27±0,25 | 5,00±0,50 | 7,67±0,76 | 10,03±0,55 |
Tp. He | - | - | 2,67±0,29 | 5,00±0,50 |
HCM EA | 6,67±0,29 | 8,40±0,36 | 9,97±0,45 | 11,60±0,36 |
Bu | 2,93±0,40 | 4,67±0,29 | 7,07±0,60 | 8,33±0,76 |
Streptomycin (0.01 mg/mL)
20,13±0,61 20,13±0,61 20,13±0,61 20,13±0,61
DMSO 10% - - - -
Ghi chú: (Trung bình ± SD, n = 3); “-”: Không ức chế; He: cao n-hexan; EA: cao ethyl acetate; Bu: cao butanol
Qua Bảng 3.7 cho thấy, ở nồng độ 5,0 mg/mL (0,5% w/v), tất cả các cao chiết phân đoạn từ cây giao thu nhận ở cả 3 vùng đều có khả năng ức chế vi khuẩn X. axonopodis pv. citri. Trong đó, hiệu quả ức chế vi khuẩn của các cao chiết phân đoạn từ cây giao ở Bình Thuận > Đắk Nông > Tp. HCM với đường kính vòng vô khuẩn
tương ứng từ 6,10 ± 0,65 mm đến 14,33 ± 0,76 mm; từ 3,07 ± 0,60 mm đến 12,33 ±
0,87 mm và từ 2,67 ± 0,29 mm đến 9,97 ± 0,45 mm. Ở nồng độ 7,5 mg/mL (0,75% w/v), cao chiết phân đoạn EA (ethyl acetate) từ cây giao thu nhận ở Bình Thuận có đường kính vòng vô khuẩn cao nhất (17,67 ± 0,57 mm) và giá trị MIC đạt 0,156 mg/mL (0,0156%) (Bảng 3.8). Trong khi đường kính vòng vô khuẩn thấp nhất (2,67 ± 0,29 mm) được quan sát thấy ở cao chiết chiết phân đoạn He (n-hexan) của cây giao thu nhận ở Tp. HCM. Ở nồng độ 1,25 mg/mL (0,125% w/v) và 2,5 mg/mL (0,25% w/v), cao chiết phân đoạn He từ cả ba vùng thu nhận đều không có khả năng ức chế vi khuẩn. Theo Sultan và ctv (2016) cho rằng, sự khác biệt về hiệu quả kháng khuẩn của các chiết xuất từ cây E. tirucalli khi sử dụng các dung môi khác nhau là do sự có mặt của các hợp chất có hoạt tính sinh học. Kết quả nghiên cứu cũng cho thấy, hiệu quả ức chế vi khuẩn X. axonopodis pv.citri của các chiết phân đoạn EA từ cây giao cao hơn so với dịch chiết ethanol từ tỏi, cây Azadirachta indica, Guava, Casto và Turmeric được báo cáo trong nghiên cứu của Negiand và Kuma (2015). Cụ thể, dịch chiết ethanol từ tỏi, cây Azadirachta indica, Guava, Casto và Turmeric với nồng độ 20% có khả năng ức chế vi khuẩn X. axonopodis pv. citri với đường kính vòng vô khuẩn tương ứng là 1,73; 1,67; 1,57; 1,43 và 1,13 cm.
Ngoài ra, trong nghiên cứu của Raju và ctv (2013), dịch chiết lá Tulasi (cây húng quế) (40%) có khả năng ức chế X. axonopodis pv. punicae với đường kính vòng vô khuẩn là 1,76 cm. Theo Ijato (2016), ở nồng độ 5% và 20%, dịch chiết A. indicia có hiệu quả ức chế vi khuẩn X. citri với đường kính vòng vô khuẩn là 1,27 cm và 2,60 cm. Trong khi đó, dịch chiết V. amygdalina có đường kính vòng vô khuẩn tương ứng là 0,82 cm và 2,20 cm. Kết quả nghiên cứu cho thấy, dịch chiết từ cây giao ở Việt Nam có khả năng ức chế vi khuẩn X. axonopodis. Nghiên cứu này là một bước quan trọng trong việc phát triển các loại thuốc trừ sâu có nguồn gốc thực vật thân thiện với môi trường để quản lý bệnh hại cây trồng do vi khuẩn và phát triển chế phẩm thương mại.
Bảng 3.8. Kết quả nồng độ ức chế tối thiểu (MIC - mg/mL) vi khuẩn X. axonopodis pv.
citri của các cao chiết phân đoạn
Vùng thu nhận
Cao chiết phân đoạn MIC (mg/mL)
Bình Thuận He -
EA 0,156
Bu 0,625
Đắk Nông He -
EA 0,312
Bu 0,625
Tp. HCM He -
EA 0,625
Bu -
Ghi chú: “-”: không xác định; He: cao n-hexan; EA: cao ethyl acetate; Bu: cao butanol

Hình 3.12. Kết quả đường kính vòng vô khuẩn đối với vi khuẩn Xanthomonas của các cao chiết từ cây giao ở nồng độ 7,5 mg/mL (0,75% w/v), kháng sinh Streptomycin (0,01 mg/mL) bằng phương pháp khuếch tán giếng thạch.
(A - cao n-hexan; B- cao etyl acetate; C - cao butanol; D - Streptomycin)
3.2.3. Kết quả định tính các nhóm hoạt chất có trong các cao chiết phân đoạn từ cây giao
Để có cơ sở khoa học khẳng định kết quả đánh giá khả năng ức chế vi khuẩn X. axonopodis pv. citri trong điều kiện phòng thí nghiệm, việc đánh giá các nhóm hoạt chất, định lượng hàm lượng phenolic tổng và flavonoid tổng và xác định sự có mặt của
các hoạt chất có mặt trong cao chiết phân đoạn là cần thiết. Các cao chiết phân đoạn từ cây giao thu nhận từ Bình Thuận và Đắk Nông có hiệu quả ức chế vi khuẩn X. axonopodis pv. citri cao hơn ở Tp. HCM nên được chọn để đánh giá sự hiện diện của các nhóm hoạt chất. Kết quả định tính các nhóm hoạt chất flavonoid, alkaloid, tannin, terpennoid và saponin trong các cao chiết phân đoạn He (n-hexan), EA (ethyl acetate) và Bu (butanol) được trình bày ở Bảng 3.9.
Qua Bảng 3.9 cho thấy, kết quả định tính các nhóm hoạt chất trong các cao chiết phân đoạn của cây giao thu nhận từ Bình Thuận và Đắk Nông là như nhau. Trong đó, các cao chiết phân đoạn từ cây giao ở Bình Thuận và Đắk Nông đều có chứa nhóm flavonoid và không có sự hiện diện của nhóm saponin, nhóm chất có chứa nhiều thành phần có độc tính đã được báo cáo trong các nghiên cứu trước đây. Kết quả này khác với báo cáo của Vale và Orlanda (2011) và Orlanda và Vale (2015) về thành phần hóa học của dịch chiết cây giao ở Brazil có chứa saponin. Điều này cho thấy, cây giao ở Việt Nam là nguồn nguyên liệu tiềm năng với nhiều hoạt chất có khả năng ức chế vi khuẩn mới. Cao chiết phân đoạn EA (ethyl acetate) và phân đoạn Bu (butanol) có chứa alkaloid, flavonoid và tannin trong khi phân đoạn He (n-hexan) có chứa flavonoid và terpenoid. Giữa các cao chiết phân đoạn ở cả hai vùng thu nhận, phân đoạn EA sở hữu nhiều nhóm hoạt chất nhất. Theo Nguyễn Kim Phi Phụng (2007); Younes và ctv (2018), thành phần các hợp chất hóa học trong các dịch chiết phụ thuộc vào độ phân cực và trọng lượng phân tử của các dung môi chiết và tuân thủ nguyên tắc “các chất giống nhau sẽ hòa tan vào nhau”. Nhóm hoạt chất flavonoid phần lớn được giữ lại ở phân đoạn EA. Tuy nhiên, một số flavonoid có gắn với phân tử đường nên độ phân cực của hợp chất cũng tăng lên nên có mặt trong phân đoạn Bu. Thành phần hóa học trong cây giao ở Bình Thuận và Đắk Nông trong nghiên cứu này sở hữu các nhóm hoạt chất tương tự trong cây giao ở Ấn Độ trong báo cáo của Upahyay và ctv (2010) và Brazil trong báo cáo của Vale và Orlanda (2011) và Orlanda và Vale (2015). Tuy nhiên, theo báo cáo của nhóm nghiên cứu Aleixo và ctv (2018), cây giao thu nhận ở vườn Piatã, ở Brazil chỉ có mặt nhóm flavonoid, không có các nhóm tannin, alkaloid, saponin. Điều này cũng đã được ghi nhận trong báo cáo của Upahyay và ctv (2010) rằng thành phần và tỷ lệ của các hợp chất thứ cấp trong thực vật thay đổi phụ thuộc vào vị trí địa lý, mùa vụ khai thác và tuổi cây.
Bảng 3.9. Kết quả định tính các nhóm hoạt chất trong các cao chiết phân đoạn
Vùng thu nhận | Cao chiết phân đoạn | Alkaloid | Flavonoid | Tannin | Terpenoid | Saponin | ||
Bình Thuận He - | + | - | + | - | ||||
EA ++ | ++ | + | +++ | - | ||||
Bu + Đắk Nông He | - | + | + | + | - | - | + | - - |
EA | ++ | ++ | + | +++ | - | |||
+ | + | + | - | - | ||||
từ cây giao
Bu
Ghi chú: (-) âm tính (không có), (+) dương tính (có ít), (++), dương tính (có), (+++) dương tính (có nhiều). He: cao n-hexan; EA: cao ethyl acetate; Bu: cao butanol
Ngoài ra, theo Sultan và ctv (2016), sự khác nhau về hoạt tính kháng khuẩn của các cao chiết từ cây giao là do bởi hoạt tính sinh học của các nhóm hoạt chất có mặt. Trong đó, cao phân đoạn EA của cây giao sở hữu các nhóm hoạt chất alkaloid, flavonoid, tannin, terpenoid. Theo các nghiên cứu trước, alkaloid có khả năng ức chế vi khuẩn thông qua cơ chế ức chế quá trình sinh tổng hợp nucleic acid của vi khuẩn. Trong khi đó, tannin lại gây độc cho vi khuẩn thông qua cơ chế gia tăng quá trình hydroxyl hóa (Cushnie và ctv, 2014; Min và ctv, 2008). Bên cạnh đó, cơ chế tiêu diệt vi khuẩn của các polyphenol đã được ghi nhận thông qua việc kìm hãm c-di-AMP, có vai trò điều khiển nhiều chức năng khác nhau trong vi khuẩn (Upahyay và ctv, 2010). Các flavonoid ức chế vi khuẩn thông qua một số cơ chế: có khả năng ức chế enzyme transpeptidase làm cho mucopeptid (yếu tố đảm bảo vi khuẩn vững chắc) không tổng hợp được; gắn lên màng nguyên sinh chất của vi khuẩn, làm thay đổi tính thẩm thấu chọn lọc của màng, làm cho một số chất cần thiết cho đời sống của vi khuẩn (nucleotid, pyrimidin, purin) lọt qua màng nguyên sinh chất ra ngoài; ức chế tổng hợp nucleotid; tác động vào DNA khuôn, ức chế tổng hợp RNA của vi khuẩn. Nhóm -OH tự do trong






